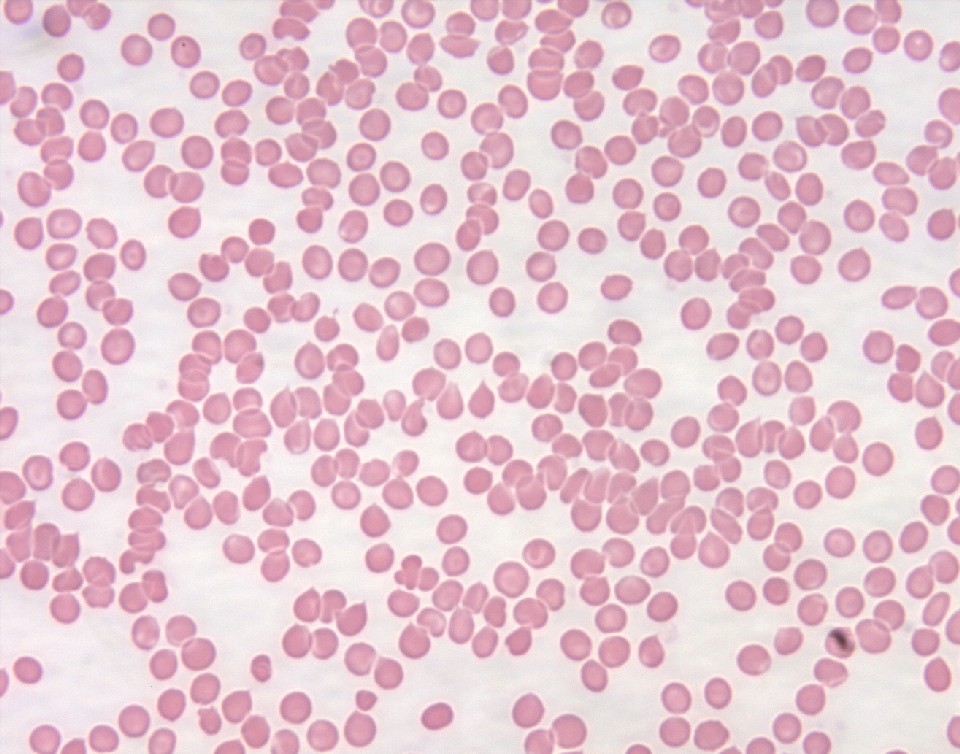
Hematology Of Leukemia Hematology Of Leukemia

What Is A Normal Blood Smear Report Nov 11 2023 0183 32 Diagnosis The American Diabetes Association ADA recommends that diabetes screening for most adults begin at age 35 The ADA advises diabetes screening before age 35
PPT Oct 13 2023 0183 32 A heart arrhythmia may feel like a fluttering pounding or racing heartbeat Some heart arrhythmias are harmless Others may cause life threatening symptoms
What Is A Normal Blood Smear Report
What Is A Normal Blood Smear Report
https://i.ytimg.com/vi/ET7oNkxLGY8/maxresdefault.jpg
Feb 28 2024 0183 32 Checking your blood pressure helps you avoid health problems Learn more about what your numbers mean
Pre-crafted templates use a time-saving service for producing a varied range of documents and files. These pre-designed formats and designs can be used for various individual and professional projects, including resumes, invitations, flyers, newsletters, reports, presentations, and more, streamlining the material production procedure.
What Is A Normal Blood Smear Report

Normal Blood Smear LM Stock Image C022 2234 Science Photo Library

Normal Blood Smear LM Stock Image C022 2204 Science Photo Library

What Is A Normal Bp Level Shop Cityofclovis
Blood Cells In Peripheral Blood Smear Hematology Society HS

Normal Blood Smear Medical Laboratories

Peripheral Blood Differential

https://zhidao.baidu.com › question
Nov 27 2015 0183 32 Normal common ordinary usual normal ordinary normal the normal temperature of the human body

https://www.mayoclinic.org › es › healthy-lifestyle › fitness › expert-answ…
Oct 8 2022 0183 32 Una frecuencia card 237 aca en reposo normal para los adultos oscila entre 60 y 100 latidos por minuto Una frecuencia card 237 aca por encima o por debajo puede indicar un problema
https://www.mayoclinic.org › tests-procedures › ferritin-test › about
Dec 19 2023 0183 32 If a ferritin test shows high ferritin levels it most often means swelling in the body called inflammation Conditions that can cause inflammation include liver disease rheumatoid

https://www.mayoclinic.org › es › diseases-conditions › low-blood-pressu…
Nov 7 2024 0183 32 Aunque lo que se considera presi 243 n arterial baja para una persona puede estar bien para otra La presi 243 n arterial baja puede no causar s 237 ntomas perceptibles O puede
https://www.mayoclinic.org › diseases-conditions › tachycardia › sympto…
Dec 15 2023 0183 32 Jeff Olsen This is a normal heartbeat HEART BEATING Atrial fibrillation interrupts this regular beat Fred Kusumoto M D Cardiology Mayo Clinic In atrial fibrillation
[desc-11] [desc-12]
[desc-13]